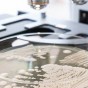

موضع البثور يكشف الحالة الصحية

المدينة نيوز :- أوردت مجلة «وومان» النمساوية أن موضع ظهور البثور يعد إشارة من البشرة على الحالة الصحية للجسم. وفيما يلي نظرة على مواضع ظهور البثور ومدلول كل منها:
على الجبين
قد يكون ظهور البثور على الجبين مؤشراً إلى قلة النوم، لذا ينبغي الحرص على النوم مدة لا تقل عن سبع ساعات كل ليلة.
فوق الحاجبين
ظهور البثور في هذا الموضع يشير إلى ضعف جهاز المناعة، وأن الإصابة بعدوى في طريقها للحدوث.
الحاجبان
هنا قد تكون التغذية هي المسؤولة، حيث قد يكمن السبب في عدم اتباع نظام غذائي متوازن، أو في عدم تحمل أحد الأغذية.
على الوجنات
قد يرجع ظهور البثور على الوجنات إلى الأوساخ والبكتيريا، التي تسد المسام، وتصل الأوساخ والبكتيريا إلى الوجنات عن طريق الأصابع أو الهاتف الجوال، لذا ينبغي الحرص على ألا يحدث تلامس بين اليد المتسخة والوجنات.
الذقن أو الرقبة
هنا تكون الهرمونات هي المسؤولة، حيث يفرز الجسم في مراحل من الدورة الشهرية هرمون التستوستيرون بكثرة، وبالتالي تفرز الغدد المزيد من الدهون، التي بدورها تسد المسام وتؤدي إلى ظهور البثور.
الأنف والجبان
ظهور البثور والشوائب بمحاذاة منطقة T يدل على التوتر النفسي الشديد، حيث يفرز الجسم الأدرينالين بكثرة، والذي بدوره يعزز من إفراز الدهون، التي تسد المسام.